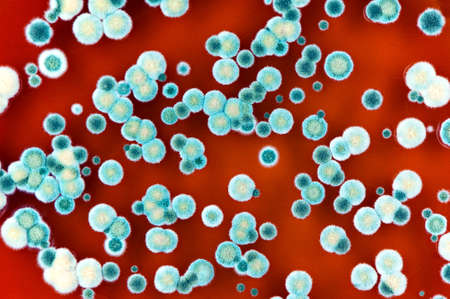
microbiology background made of colorful fungi and mold colonies. Surface of agar petri dish.の写真素材

写真素材 - microbiology background made of colorful fungi and mold colonies. Surface of agar petri dish.
作品情報
microbiology background made of colorful fungi and mold colonies. Surface of agar petri dish.
- ID:104313489
- 作品種別:写真
- 作者名:Grzegorz Skaradzi?ski
キーワード
- agar
- background
- bacteria
- bacterium
- biology
- biotechnology
- cell
- cells
- colonies
- colorful
- culture
- dish
- fungi
- growth
- health
- lab
- laboratory
- macro
- medical
- medicine
- micro
- microbial
- microbiology
- microorganism
- microorganisms
- microscope
- microscopic
- mold
- organism
- research
- safety
- science
- scientific
- surface
- abstract
類似作品
Colorful variet...
close-up of col...
Microscopic Vie...
petri dish with...
Close-up detail...
Macro close up ...
This striking i...
Colorful abstra...
petri dish with...
Laboratory petr...
Rather crazy, r...
Colorful micros...
close-up of vib...
This image appe...
Abstract backgr...
Colorful micros...
A close-up imag...
Close-up view o...
Bacterial colon...
Digital germs m...
Macro close up ...
a close up of c...
Exploring vibra...
High resolution...
Bacteria and vi...
Abstract biolog...
Red bubbles of ...
A colorful wate...
Diverse colorfu...
research biolog...
Colorful viruse...
This visualizat...
Magnifying glas...
Microscopic org...
a close up imag...
Blue bacteria a...
Close up of vir...
High-res image ...
Dynamic motion ...
Close up of vir...
Probiotics Bact...
Close up of vir...
A series of bac...
Colorful bacter...
3d render of vi...
Close up view r...
Medical test tu...
Macro close up ...
Healthy gut rep...